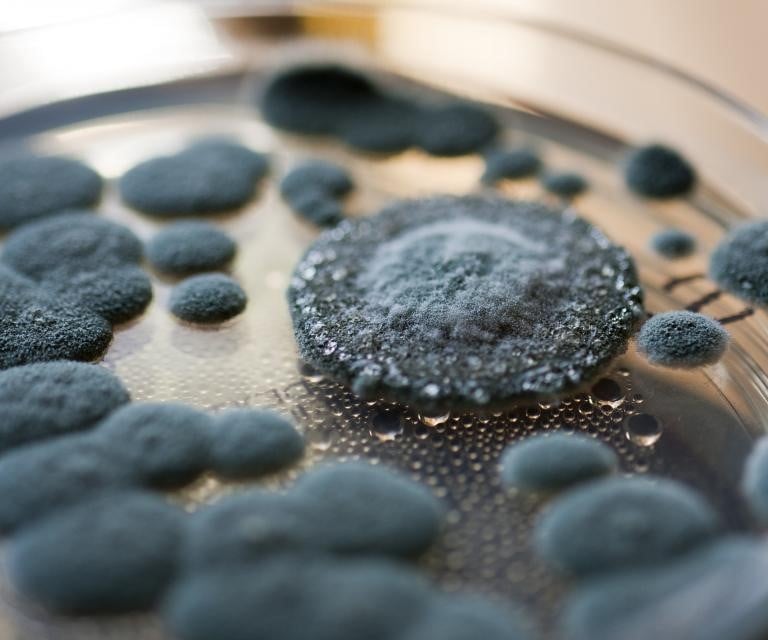
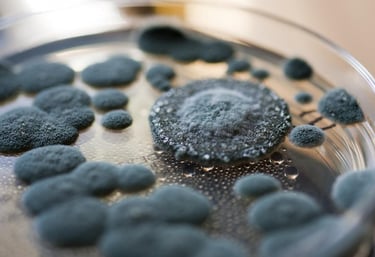

Mold Removal Ottawa – Certified Mold Remediation Specialists
MOLD REMOVALin OTTAWA
We Are Proud To Say Mold Removal Ottawa is Number of Certified AMRT Technicians in The Ottawa Area, and are Specialists in Black Mold Removal. We Follow the S520 Standard of Care That is Set Out By The IICRC Which is The Governing Certification Body For the Cleaning and Restoration Industry. Our Focus is On Safety of The Occupants of the Home While Getting Exceptional Results.
Mold Testing
Thorough testing to identify mold presence quickly.
Safe and effective removal of black mold.
Attic Mold Solutions
Best Prices
Expert Mold Removal Services in Ottawa
At Ottawa Mould, we specialize in comprehensive mold removal services, including black mold removal and testing, ensuring your home is safe and healthy at the best prices in the area.
Highly recommend their mold removal services!
Near Me
"
Mold Removal Services
Expert mold removal services in Ottawa, Ontario, ensuring a safe and healthy environment for you.

Black Mold Removal
Specialized in black mold removal, ensuring your home is safe and free from harmful spores.
Mold Testing
Comprehensive mold testing services to identify and address mold issues in your property effectively.
Customer Reviews
Hear from our satisfied clients about our mold removal services.
Ottawa Mould provided exceptional service, removing black mold in my attic quickly and effectively. Highly recommend for anyone needing mold experts!
Jessica A.
Ottawa
Mark S.
Intiaz RahimFriday, November 24th 2017
I had contacted Ottawa Mold Removal complete a project that a previous company didn’t. We contracted Shawn Rankin of IAQ Ottawa to obtain air quality samples. The testing was completed quickly, and a report was created along with a list of recommended remediation contractors. The report outlined the scope of work for the remediation project. The first company to answer was Ottawa Mold / Ottawa Extreme Cleaning. Dan from Ottawa Mold Pro arrived and quickly assessed the situation and prepared a logical course of action based on the IAQ Report. The project consisted of basement water damage causing mold and mildew resulting in a musty odor. The basement remediation encompassed moving out affected objects, sealing off the area, apply negative air pressure, run\air scrubbers with HEPA filters, complete demolition of suspect building materials, disposal, duct cleaning, anti microbial fogging on all surfaces, dusting and tidying up of the entire residence. Moreover, the source of the problem was identified and addressed.
It was evident that Dan was very professional, passionate and knowledgeable due to his years of experience in the business. Dan not once said no or made up excuses, he kept in daily contact as the project unfolded and he was always available and most importantly went the extra mile. Recommended!
★★★★★
★★★★★
Ottawa Mould offers expert mold removal services in Ottawa, Ontario, and surrounding areas. We specialize in black mold removal and mold testing.
Ottawa, Ontario, Canada
Hours
9 AM - 5 PM

Mold growth in homes is a serious concern that many Ottawa residents may overlook until it becomes a health issue. Mold is not only unsightly but can also have significant effects on the respiratory system. Understanding the connection between mold and respiratory health is crucial for homeowners in Ottawa, where humidity levels and aging homes create ideal conditions for mold growth. In this article, we will explore how mold affects respiratory health and what steps Ottawa homeowners can take to prevent and address mold growth through mold removal in Ottawa.
What is Mold and How Does it Grow in Homes?
Mold is a type of fungus that thrives in damp, humid environments. It reproduces through spores that spread through the air and can settle on surfaces, where they grow when exposed to moisture. Common indoor molds include species such as Aspergillus, Cladosporium, and Stachybotrys (black mold).
Mold requires moisture to grow, which is why it is frequently found in areas of the home where water damage or high humidity is present, such as basements, bathrooms, and attics. In Ottawa, the seasonal fluctuations in temperature and humidity contribute to mold growth, particularly in older homes that may have structural issues like leaks or poor insulation. It’s important for homeowners to recognize the conditions that promote mold and take steps to mitigate the risks.
The Respiratory Health Risks of Mold Exposure
Mold exposure is linked to several respiratory health problems. The most common issues include allergic reactions, asthma, chronic coughing, and sinus congestion. Mold spores, when inhaled, can trigger these conditions, especially in sensitive individuals. People with asthma or respiratory diseases are at a higher risk of experiencing exacerbated symptoms, which can lead to more severe health issues over time.
For Ottawa residents, the humid summers and cold winters can create the perfect breeding ground for mold, especially in homes that have had water damage due to flooding or condensation. Even if the mold is not visibly present, its spores can still be in the air, causing respiratory distress in those who are exposed to it regularly.
Mold Growth in Ottawa Homes: Specific Concerns
Ottawa’s climate presents unique challenges for homeowners trying to avoid mold growth. During the humid summer months, moisture can accumulate in the home, and without proper ventilation, mold can start to grow. In winter, the cold air outside can lead to condensation on walls and windows, creating the perfect environment for mold to thrive.
Older homes in Ottawa are particularly susceptible to mold growth due to outdated insulation, poor ventilation, and the likelihood of hidden leaks in the plumbing. Homeowners who experience basement flooding, roof leaks, or faulty windows should be especially diligent about monitoring for mold growth and taking preventive measures.
Identifying Mold-Related Health Symptoms
If you suspect that mold might be affecting your home, it’s essential to watch for signs of respiratory issues, especially in family members who may be particularly sensitive. Common symptoms of mold exposure include:
Persistent coughing or wheezing
Nasal congestion or a runny nose
Sneezing, especially in the morning
Irritation of the throat, eyes, or skin
Fatigue and general malaise
Press enter or click to view image in full size
For Ottawa homeowners, recognizing these symptoms early can prevent further complications. If anyone in your household is experiencing these issues and you suspect mold may be the culprit, seeking mold removal in Ottawa should be a priority. Early intervention can help mitigate health risks and protect the home’s occupants from ongoing exposure.
Mold Prevention and Remediation in Ottawa Homes
Preventing mold growth in Ottawa homes is possible with proper maintenance and attention to moisture control. Key steps to prevent mold include:
Control Humidity Levels: Keep indoor humidity levels below 60%. This can be achieved using dehumidifiers, especially in areas like basements or bathrooms.
Improve Ventilation: Proper ventilation is essential in areas prone to moisture, such as bathrooms and kitchens. Ensure that vents lead outdoors, not into attics or crawl spaces.
Fix Leaks Quickly: Water leaks are the most common way mold enters a home. Whether it’s a leaking pipe, a roof leak, or condensation around windows, repairing leaks as soon as they occur can help prevent mold from taking hold
Routine Inspections: Regularly check areas where mold is more likely to grow, such as the basement, attic, and behind appliances. If you spot early signs of mold growth, act immediately by calling in a professional for mold removal in Ottawa.
If mold has already taken hold in your home, it’s important to enlist the help of professional mold remediation services. Mold removal in Ottawa involves specialized equipment and techniques to ensure that the mold is fully removed, and the underlying moisture problems are addressed. Trying to remove mold yourself can sometimes make the issue worse, as mold spores can spread if not properly contained.
Protect Your Health: The Importance of Mold Removal in Ottawa Homes
If you suspect mold is affecting your home, taking action is crucial not only for the well-being of your property but also for the health of your family. Mold removal in Ottawa is essential for eliminating mold-related health risks and improving indoor air quality. Professional remediation services can safely remove the mold, identify the source of moisture, and provide recommendations for keeping your home mold-free.
Take Action Today
Don’t wait until mold affects your health. If you suspect mold in your home, contact a professional mold removal company in Ottawa right away. By addressing mold issues early, you can prevent respiratory health problems and ensure that your home remains a safe, healthy place for you and your family.
Press enter or click to view image in full size
If you live in Ottawa and are concerned about mold in your home, make sure to schedule an inspection with a trusted mold removal in Ottawa expert. Protect your home and your health by taking the necessary steps today.
ottawa mould
Contact
Support
mould
© 2024. All rights reserved.
